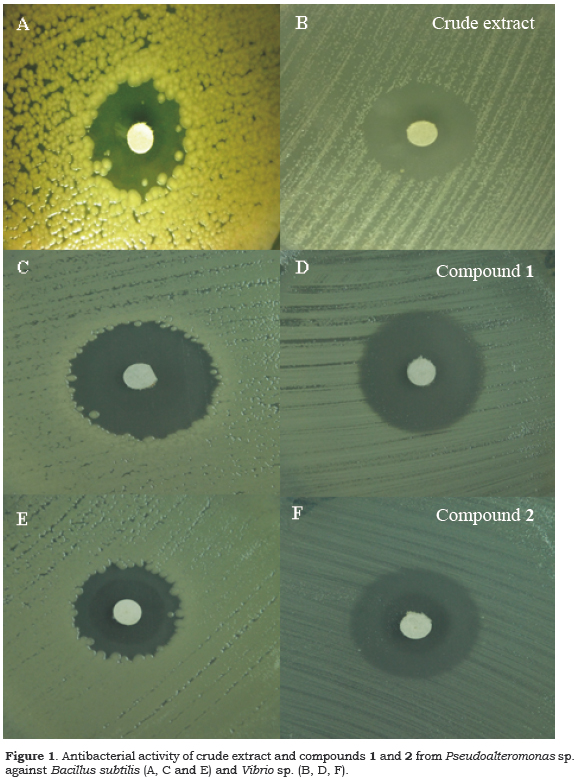

Servicios Personalizados
Revista
Articulo
Indicadores
-
Citado por SciELO -
Accesos
Links relacionados
-
Similares en
SciELO
Compartir
Revista latinoamericana de química
versión impresa ISSN 0370-5943
Rev. latinoam. quím vol.39 no.1-2 Naucalpan de Juárez 2011
Antibacterial constituents from the octocoral-associated bacterium Pseudoalteromonas sp.
Sergio Martínez-Luis, Javier Ballesteros, Marcelino Gutiérrez*
Center for Drug Discovery, Institute for Scientific Research and Technology Services (INDICASAT), Clayton, City of Knowledge 0843-01103, Republic of Panama. *Corresponding author: Tel.: 507-5170732 Fax: 507-5170701, e-mail: mgutierrez@indicasat.org.pa.
Received September 2011.
Accepted December 2011.
ABSTRACT
Bioassay guided fractionation of the ethyl acetate extract obtained from the bacterium Pseudoalteromonas sp. isolated from the octocoral Leptogorgia alba led to the isolation of two known diketopiperazines identified as cyclo-(L-Ph-L-Pro) (1), and cyclo-(L-Leu-L-Pro) (2). Structures of 1-2 were defined based on their spectroscopic data, including NMR, HRESITOF-MS and optical rotations, and their comparison with the spectroscopic data reported in the literature. Both, compounds 1 and 2 showed strong inhibition on the growth of Bacillus subtillis and Vibrio sp. Analysis of the crude extract using APCI-MS revealed the presence of other compounds of the diketopiperazine family.
Keywords: Pseudoalteromonas sp., Bacillus subtilis, Vibrio sp., diketopiperazines, antibiotics.
RESUMEN
El asilamiento biodirigido del extracto de acetato de etilo obtenido de la bacteria Pseudoalteromonas sp. aislada del octocoral Leptogorgia alba llevó al aislamiento de dos dicetopiperazinas conocidas, identificadas como cyclo-(L-Ph-L-Pro) (1), y cyclo-(L-Leu-L-Pro) (2). Las estructuras de los compuestos 1 -2 fueron establecidas mediante análisis espectroscópico incluyendo RMN, ESITOF-MS y rotación óptica, y mediante su comparación con datos de la literatura. Los compuestos 1 -2 mostraron una fuerte inhibición del crecimiento de Bacillus subtillis y Vibrio sp. El análisis del extracto crudo mediante espectrometría de masas APCI reveló la presencia de otros compuestos de la serie de las dicetopiperazinas.
Palabras clave: Pseudoalteromonas sp., Bacillus subtilis, Vibrio sp., dicetopiperacinas, antibióticos.
INTRODUCTION
Antibiotic resistance of pathogenic bacteria is a major public health problem worldwide associated with increased rates of morbidity, mortality and increased health care costs for treatment of people infected by antibiotic resistant strains of bacteria (Gwynn et al., 2010). Additionally, resistance to antibiotics has led to a significant economic impact because it has increased the cost of treating infections, plus it also has contributed to increases in morbidity and mortality (Hõgberg et al., 2010). The number of new antibiotics introduced to the market has declined significantly over the past 20 years, despite the increasing problems with antimicrobial resistance among important bacterial pathogens (Moellering Jr. 2011; Gwynn et al., 2010). Among the reasons leading to the reduction in the development of new antimicrobial agents are: 1) classical approaches of drug discovery have produced poor results due to the difficulty involved in obtaining new compounds; 2) new approaches, such as microbial genomics and high throughput screening, have not provided sufficient results yet, and 3) a lack of interest by major pharmaceutical companies in the development of new antimicrobials (Moellering Jr. 2011). For these reasons, there is an urgent need to seek new alternatives to current antibiotics.
Among the antibiotics available, a large group of low molecular weight compounds with antimicrobial activity were isolated from natural terrestrial sources during the past two decades (Butler and Cooper 2011; Hughes and Fenical 2010). The evolution of pathogenic bacteria resistant to antibiotics has stimulated the search for new antimicrobial agents from alternative sources, including sources from the ocean. In recent years, marine organisms have been investigated as potential producers of compounds with pharmaceutical application (Hughes and Fenical 2010). Thus, the current study was designed to investigate the antibacterial activity of the bacterium Pseudoalteromonas sp. associated with the octocoral Leptogorgia alba collected from Otoque Island, Pacific coast of Panama. Herein we report the isolation, identification and antibacterial activity of compounds 1-2 produced by Pseudoalteromonas sp.
MATERIAL AND METHODS
General Experimental Procedures.
Optical rotations were measured with a Jasco P-2000 polarimeter. NMR spectra were acquired on Jeol Eclipse 400 MHz spectrometer and referenced to residual solvent 1H and 13C signals (δH 7.26, δC 77.0 for CDCl3). Low-resolution eSiMS spectra were acquired on Jeol LC-mate mass spectrometer, while high-accuracy mass measurements were obtained on an Agilent 6230 mass spectrometer. The purification of the compounds was carried out on Agilent 1100 HPLC system equipped with a quaternary pump, a diode array detector, and a normal phase silica gel column (Phenomenex Sphereclone, 4.6 mm x 100 mm, 5 μm) at a flow rate of 0.75 mL/min. Pre-fractionation of the extract was carried out using supelclean™ LC-18 solid phase extraction (SPE) tubes. TLC (analytical) was performed on precoated silica gel 60 F254 plates (Merck). All solvents were HPLC grade and used without further purification.
Biological material collection and identification.
A healthy specimen of the octocoral Lep-togorgia alba was collected by hand using SCUBA near Otoque Island in the Pacific Ocean off the coast of Panama in August 2009. A small piece of the coral was rinsed with sterile seawater and a small portion of the coral mucus was inoculated on Petri dishes with seawater-based nutrient media.
A total of 34 bacterial isolates were obtained from these collection plates. All strains were evaluated for their antimicrobial activity and one strain was found to inhibit the growing of Bacillus subtillis and Vibrio sp. Taxonomy of this active bacterium was carried out by sequencing of the 1317 bp of 16S rRNA gene. The gene sequence was submitted to The Ribosomal Database Project (RDP) (Michigan State University) and showed 100% similarity to 16S rRNA gene sequence of a strain identified in RDP like Pseudoalteromonas sp.
Fermentation and extraction
The bacterium Pseudoalteromonas sp. was inoculated in two Erlenmeyer flasks (500 mL), containing 250 mL of medium M1 (Agar, starch of potatoes, yeast extract and peptone) and 250 mL of medium M3 (Agar, yeast extract, peptone and glycerol). Erlenmeyer flasks were placed in an orbital shaker at 172 rpm at room temperature for 10 days. After this period, the culture broths (M1 and M3) were extracted separately with ethyl acetate (200 mL x 3). The organic extracts were washed with distillated water (200 mL x3) in order to remove traces of culture media from the organic extract. The extracts were then dried under reduced pressure to obtain 22 mg and 16.5 mg of crude extracts from M1 and M3 mediums, respectively.
Isolation of antibiotics.
Extract obtained from M1 medium (20 mg) was fractionated using C-18 solid phase extraction (SPE) cartridges eluted with a stepwise gradient of 20%, 40%, 60%, 80%, and 100% of methanol in water to yield 5 fractions (F1-F5). Fraction F5 eluted with 100 % methanol, was purified by normal phase HPLC (Sphereclone silica 250 x 10 mm column, isocratic elution of 85% hexanes : 15% EtOAc, UV detector at 254 nm, flow of 0.75 mL/min) to afford 0.9 mg of ciyclo-(L-Ph-L-Pro) (1) and 1.0 mg of ciyclo-(L-Leu-L-Pro) (2).
Cyclo-(L-Ph-L-Pro) (1). Colorless oil; [α]25D -60.6 (c 0.66, EtOH); 1H NMR (CDCl3, 400 MHz): δ: 7.20 - 7.36 (5H, m, Ar-H), 5.61 (1H, brs, NH), 4.25 (1 H, dd, J = 10.0, 3.0 Hz, H-9), 4.05 (1H, t, J = 8.0, Hz, H-6), 3.53-3.63 (2H, m, H-3), 2.76 (2H, dd, J = 14.0, 10.0 Hz, H-10), 2.29-2.35 (2H, m, H-5), 1.95-2.03 (1H, m, H-4b), 1.86-1.91 (1H, m, H-4a); 13C (CDCl3, 100 MHz): δ: 169.2 (C-1), 164.7 (C-7), 135.7 (C-1'), 129.0 (C-21), 128.8 (C-3'), 127.3 (C-4'), 58.9 (C-6), 55.9 (C-9), 45.2 (C-3), 36.5 (C-10), 28.1 (C-5), 22.3 (C-4); HR-ESI-TOFMS m/z 267.1104 [M + Na]+, C14H16N2O2Na requires 267.1109).
Cyclo-(L-Leu-L-Pro) (2): Colorless oil, [α]25D -15.9 (c 0.66, EtOH); 1H NMR (CDCl3, 400 MHz): δ: 6.07 (1H, brs, NH), 4.10 (1 H, t, J = 7.8 , H-6), 4.00 (1H, dd, J = 8.3, 4.0 Hz, H-9), 3.45-3.61 (2H, m, H-3), 2.29-2.35 (2H, m, H-5), 1.98-2.16 (2H, m, H-4), 1.84-1.92 (1H, m, H-11), 1.72 (1H, m, H-10b), 1.51 (1H, m, , H-10a), 0.97 (3H, d, J = 7.0, CH3), 0.93 (3H, d, J = 7.0, CH3); 13C (CDCl3, 100 MHz): δ: 170.1 (C-1), 166.2 (C-7), 59.1 (C-6), 53.5 (C-9), 45.6 (C-3), 38.7 (C-10), 28.2 (C-5), 24.8 (C-11), 23.4 (C-4), 22.8 (C-12), 21.3 (C-12'); HR-ESI-TOFMS m/z 211.1441 [M + H]+, C11H19N2O2 requires 211.1447).
Screening for bacterial antagonistic activity
Pseudoalteromonas sp. was screened for antibacterial activity according to the method described by Castillo and collaborators (Castillo et al., 2001) with some modifications. The method consisted in spreading a suspension of 1 x 105 CFU of the target bacteria (Bacillus subtilis, Staphylococcus aureus, Klebsiella sp., Pseudomonas aeruginosa and Vibrio sp.) on Petri dishes with M1 agar. After 20 minutes a small cluster of Pseudoalteromonas sp. was placed on the agar plate, followed by overnight incubation at 37 °C. After this period, the plates were observed for the formation of inhibition zones around the Pseudoalteromonas sp. clusters.
Antimicrobial activity
The antimicrobial activity of extracts and pure compounds obtained from Pseudoalteromonas sp. was evaluated using the disc diffusion susceptibility test according to the National Committee for Clinical Laboratory Standards (Espinel-Ingroff and Canton 2007). Briefly, the disc diffusion test was carried out by spreading 500 μL of a suspension of 1x105 CFU/mL of the target bacteria (B. subtilis, S. aureus, P. aeruginosa, Klebsiella sp. and Vibrio sp.) on agar plates with a sterile cotton swab. After 10 minutes 6 mm diameter paper discs containing the extracts or compounds (100 μg/disc) obtained from Pseudoalteromonas sp. were applied and incubated at 37°C for 24 h. After this period the inhibition zones were measured. Discs containing 100 μg of chloramphenicol were used as positive controls, whereas discs containing 10 μL of ethyl acetate were used as negatives controls for each experiment. Each test was performed in duplicate.
RESULTS AND DISCUSSION
The bacterium Pseudoalteromonas sp. was isolated from the mucus of the octocoral L. alba collected near Otoque Island in the Pacific of Panama. Taxonomic identification of the bacterium was done based on its 16S rRNA sequence.
Pseudoalteromonas sp. was evaluated for its antagonistic activity against several target bacteria (Bacillus subtilis, Staphylococcus aureus, Pseudomonas aeruginosa, Vibrio sp. and Klebsiella sp.) and it was found to be active against Vibrio sp. and B. subtilis with inhibition zones of 21 mm and 16 mm, respectively.
In order to isolate the active compounds, the organic extract of Pesudoalteromonas sp. obtained from M1 medium was fractionated by C-18 SPE, followed by normal phase HPLC purification to yield the diketopiperazines 1-2. Compounds 1 and 2 were identified as cyclo-(L-Ph-L-Pro) and cyclo-(L-Leu-L-Pro), respectively, by spectroscopic analysis including HRESITOF-MS, NMR, and optical rotations. The structures were confirmed by comparison of their spectroscopic data with those reported in the literature (Li et al., 2006; Capon et al., 2007; Furtado et al., 2005; Fdhila et al., 2003; Fdhila et al., 2006).
Antibacterial activity of compounds 1-2 against Bacillus subtilis and Vibrio sp. was evaluated using the disc diffusion susceptibility test in agar plates. Compound 1 showed inhibition zones of 25 mm against Bacillus subtilis and 14.5 mm against Vibrio sp., while compound 2 showed inhibition zones of 23 mm against Bacillus subtilis and 24 mm against Vibrio sp. (Figure 1).
The fact that diketopiperazines 1 -2 inhibit the growing of B. subtilis, a Gram positive bacterium, and Vibrio sp., a Gram negative bacterium, indicates their broad spectrum activity.

Marine diketopiperazines have been isolated mainly from microorganisms and there are a few reports on their isolation from marine invertebrates (Huang et al., 2010). The fact that this family of compounds is widely produced by microorganisms, strongly suggests that the "marine invertebrate-derived diketopiperazines" might also have a microbial biosynthetic origin. To our knowledge, this is the first report on diketopiperazines from a bacterium associated with an octocoral.
It is well documented that corals hold a complex microbial community in their mucus (Sunagawa et al., 2010; Shnit-Orland and Kushmaro, 2009; Ritchie, 2006). However, the ecological role of these microbes in the coral holobiont remains largely unknown. It has been proposed that bacterial communities in the coral mucus provide defense against coral pathogens by production of antibiotics (Ritchie, 2006; Shnit-Orland and Kushmaro, 2009).
Among pathogens that affect the coral health, bacteria of the genus Vibrio have been found to produce several coral diseases (Vidal-Dupiol et al., 2011). The fact that compounds 1-2 were isolated from an octocoral-associated bacterium, together with the fact that compounds 1 -2 possess antibiotic activity against a marine strain of Vibrio, support the hypothesis that corals are chemically defended by their associated bacteria.
Due to the small amount of crude extract obtained, we only isolated compounds 1 and 2. However, to learn more about the metabolites produced by this bacterium, we analyzed the crude extract obtained from medium M1 by LC-MS. Using this technique we detected the presence of other diketopiperazines including cyclo-(Val-Pro), cyclo-(Leu-4-OH-Pro), cyclo-(Phe-4-OH-Pro) and cyclo-(Trp-Pro) (Figure 3).
To explore the effect of different culture media on the production of secondary metabolites by Pseudoalteromonas sp., we cultured the bacterium using two different media M1 and M3. Analysis of the extracts by APCI-MS indicated that Pseudoalteromonas sp. produced a chemical profile quite similar using both M1 and M3 medium. (Figures 3-4).
CONCLUSIONS
The bacterium Pseudoalteromonas sp. associated with the octocoral L. alba showed antagonistic activity against Vibrio sp. and B. subtilis. Bioassay guided fractionation of the crude extract resulted in the isolation of two diketopiperazines 1 -2. Compounds 1 - 2 were responsible for the antibacterial activity presented by Pseudoalteromonas sp., and they are not selective for Gram positive or Gram negative bacteria. Analysis of the crude extract by liquid chromatography coupled to a mass spectrometer revealed the presence of more compounds of the diketopiperazine series. Isolation and characterization of the additional diketopiperazine's detected in the Pseudoalteromanas sp. extract is required to confirm if they also possess antibacterial activity.
ACKNOWLEDGMENTS
We gratefully acknowledge the Government of Panama (ANAM, ARAP) for granting permission to make these collections; to J. Sánchez, and Dr. J. Martínez and R. Gavilan for the taxonomic identification of the bacterium. This work was partially supported by the National Secretariat for Science and Technology of Panama (SENACYT, grant number COL09-047), INDICASAT-AIP, and the Fogarty International Center's International Cooperative Biodiversity Groups program (grant number TW006634).
REFERENCES
Butler, M.S., Cooper, M.A. (2011) Antibiotics in the clinical pipeline in 2011. The Journal of Antibiotics 64 : 413-425. [ Links ]
Capon, R.J., Stewart, M., Ratnayake, R., Lacey, E., Gill, J.H. (2007) Citromycetins and bilains A-C: new aromatic polyketides and diketopiperazines from Australian marine-derived and terrestrial Penicillium spp. Journal of Natural Products 70 : 1746-52. [ Links ]
Castillo, I., Lodeiros, C., Núñez, M., Isabel, C. (2001) Evaluación in vitro de sustancias antibacterianas producidas por bacterias aisladas de diferentes organismos marinos. Revista de Biología Tropical 49 : 1213-1221. [ Links ]
Espinel-Ingroff, A., Cantón, E. (2007) Antifungal Susceptibility Testing of Yeasts. In Schwalbe, R., Steele-Moore, L., Goodwin, A. (eds) Antimicrobial Susceptibility Testing Protocols. US: CRC Press LLC, pp.199-204. [ Links ]
Fdhila, F., Vázquez, V., Sánchez, J.L., Riguera, R. (2003) DD-diketopiperazines: antibiotics active against Vibrio anguillarum isolated from marine bacteria associated with cultures of Pecten maximus. Journal of Natural Products 66 : 1299-1301. [ Links ]
Fdhila, F., Vázquez, V., Sánchez, J.L., Riguera, R. (2006) DD-diketopiperazines: antibiotics active against Vibrio anguillarum isolated from marine bacteria associated with cultures of Pecten maximus. Journal of Natural Products 69 : 1120-1120. [ Links ]
Furtado, N.A.J.C., Pupo, M.T., Carvalho, I., Campo, V.L., Duarte, M.C.T., Bastos, J.K. (2005) Diketopiperazines Produced by an Aspergillus fumigatus Brazilian Strain. Journal Of The Brazilian Chemical Society 16 : 1448-1453. [ Links ]
Gwynn, M.N., Portnoy, A., Rittenhouse, S.F., Payne, D.J. (2010) Challenges of antibacterial discovery revisited. Annals of the New York Academy of Sciences 1213 : 5-19. [ Links ]
Hõgberg, L.D., Heddini, A. Cars (2010) The global need for effective antibiotics: challenges and recent advances. Trends in Pharmacological Sciences 31 : 509-515. [ Links ]
Hughes, C. C., Fenical, W. (2010) Antibacterials from the sea. Chemistry (Weinheim and Der Bergstrasse, Germany) 16 : 12512-12525. [ Links ]
Huang , R., Zhou, X., Xu, T., Yang, X., Liu, Y. (2010) Diketopiperazines from marine origin. Chemistry and Biodiversity 7 : 2809-2829. [ Links ]
Li, X., Dobretsov, S., Xu, Y., Xiao, X., Hung, O. S., Quian, P. (2006) Antifouling diketopiperazines produced by a deep-sea bacterium, Streptomyces fungicidicus. Biofouling 22 : 187-194. [ Links ]
Moellering Jr, R.C. (2011) Discovering new antimicrobial agents. International Journal of Antimicrobial Agents 37 : 2-9. [ Links ]
Ritchie, K. B. (2006) Regulation of microbial populations by coral surface mucus and mucus-associated bacteria. Marine Ecology Progress Series 322 : 1-14. [ Links ]
Shnit-Orland, M., Kushmaro, A. (2009) Coral mucus-associated bacteria: a possible first line of defense. Federation European Microbiological Society Microbiology Ecology 67 : 371-380. [ Links ]
Sunagawa, S., Woodley, C. M., Medina, M. (2010) Threatened corals provide underexplored microbial habitats. Plos One 5 : e9554. [ Links ]
Vidal-Dupiol, J., Ladrière, O., Meistertzheim, A. L., Fouré, L., Adjeroud, M., Mitta, G. (2011) Physiological responses of the scleractinian coral Pocillopora damicornis to bacterial stress from Vibrio coralliilyticus. The Journal of Experimental Biology 214 : 1533-1545. [ Links ]












